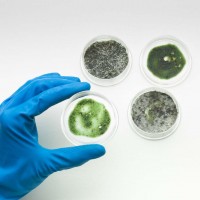
Gallery thumbnail

Heron Sight
Last time updated: 2/28/23, 9:56 PM
About
Serving a 40-mile radius around Sunrise, Heron Sight is an experienced mold inspection and air quality control company available for both residential and commercial properties. This family-owned and operated business boasts a professional team that will inspect and test your premises for signs of mold and deals with the issue appropriately by removing the mold and extracting any residual water, ensuring a healthy environment for your home or business. Contact them today for more information!
Images

Frequently Asked Questions
When was Heron Sight founded?
Heron Sight was founded in 2016.
Attention business owner!
Register your business now and enhance your global reach with iGlobal.
Copied to clipboard!